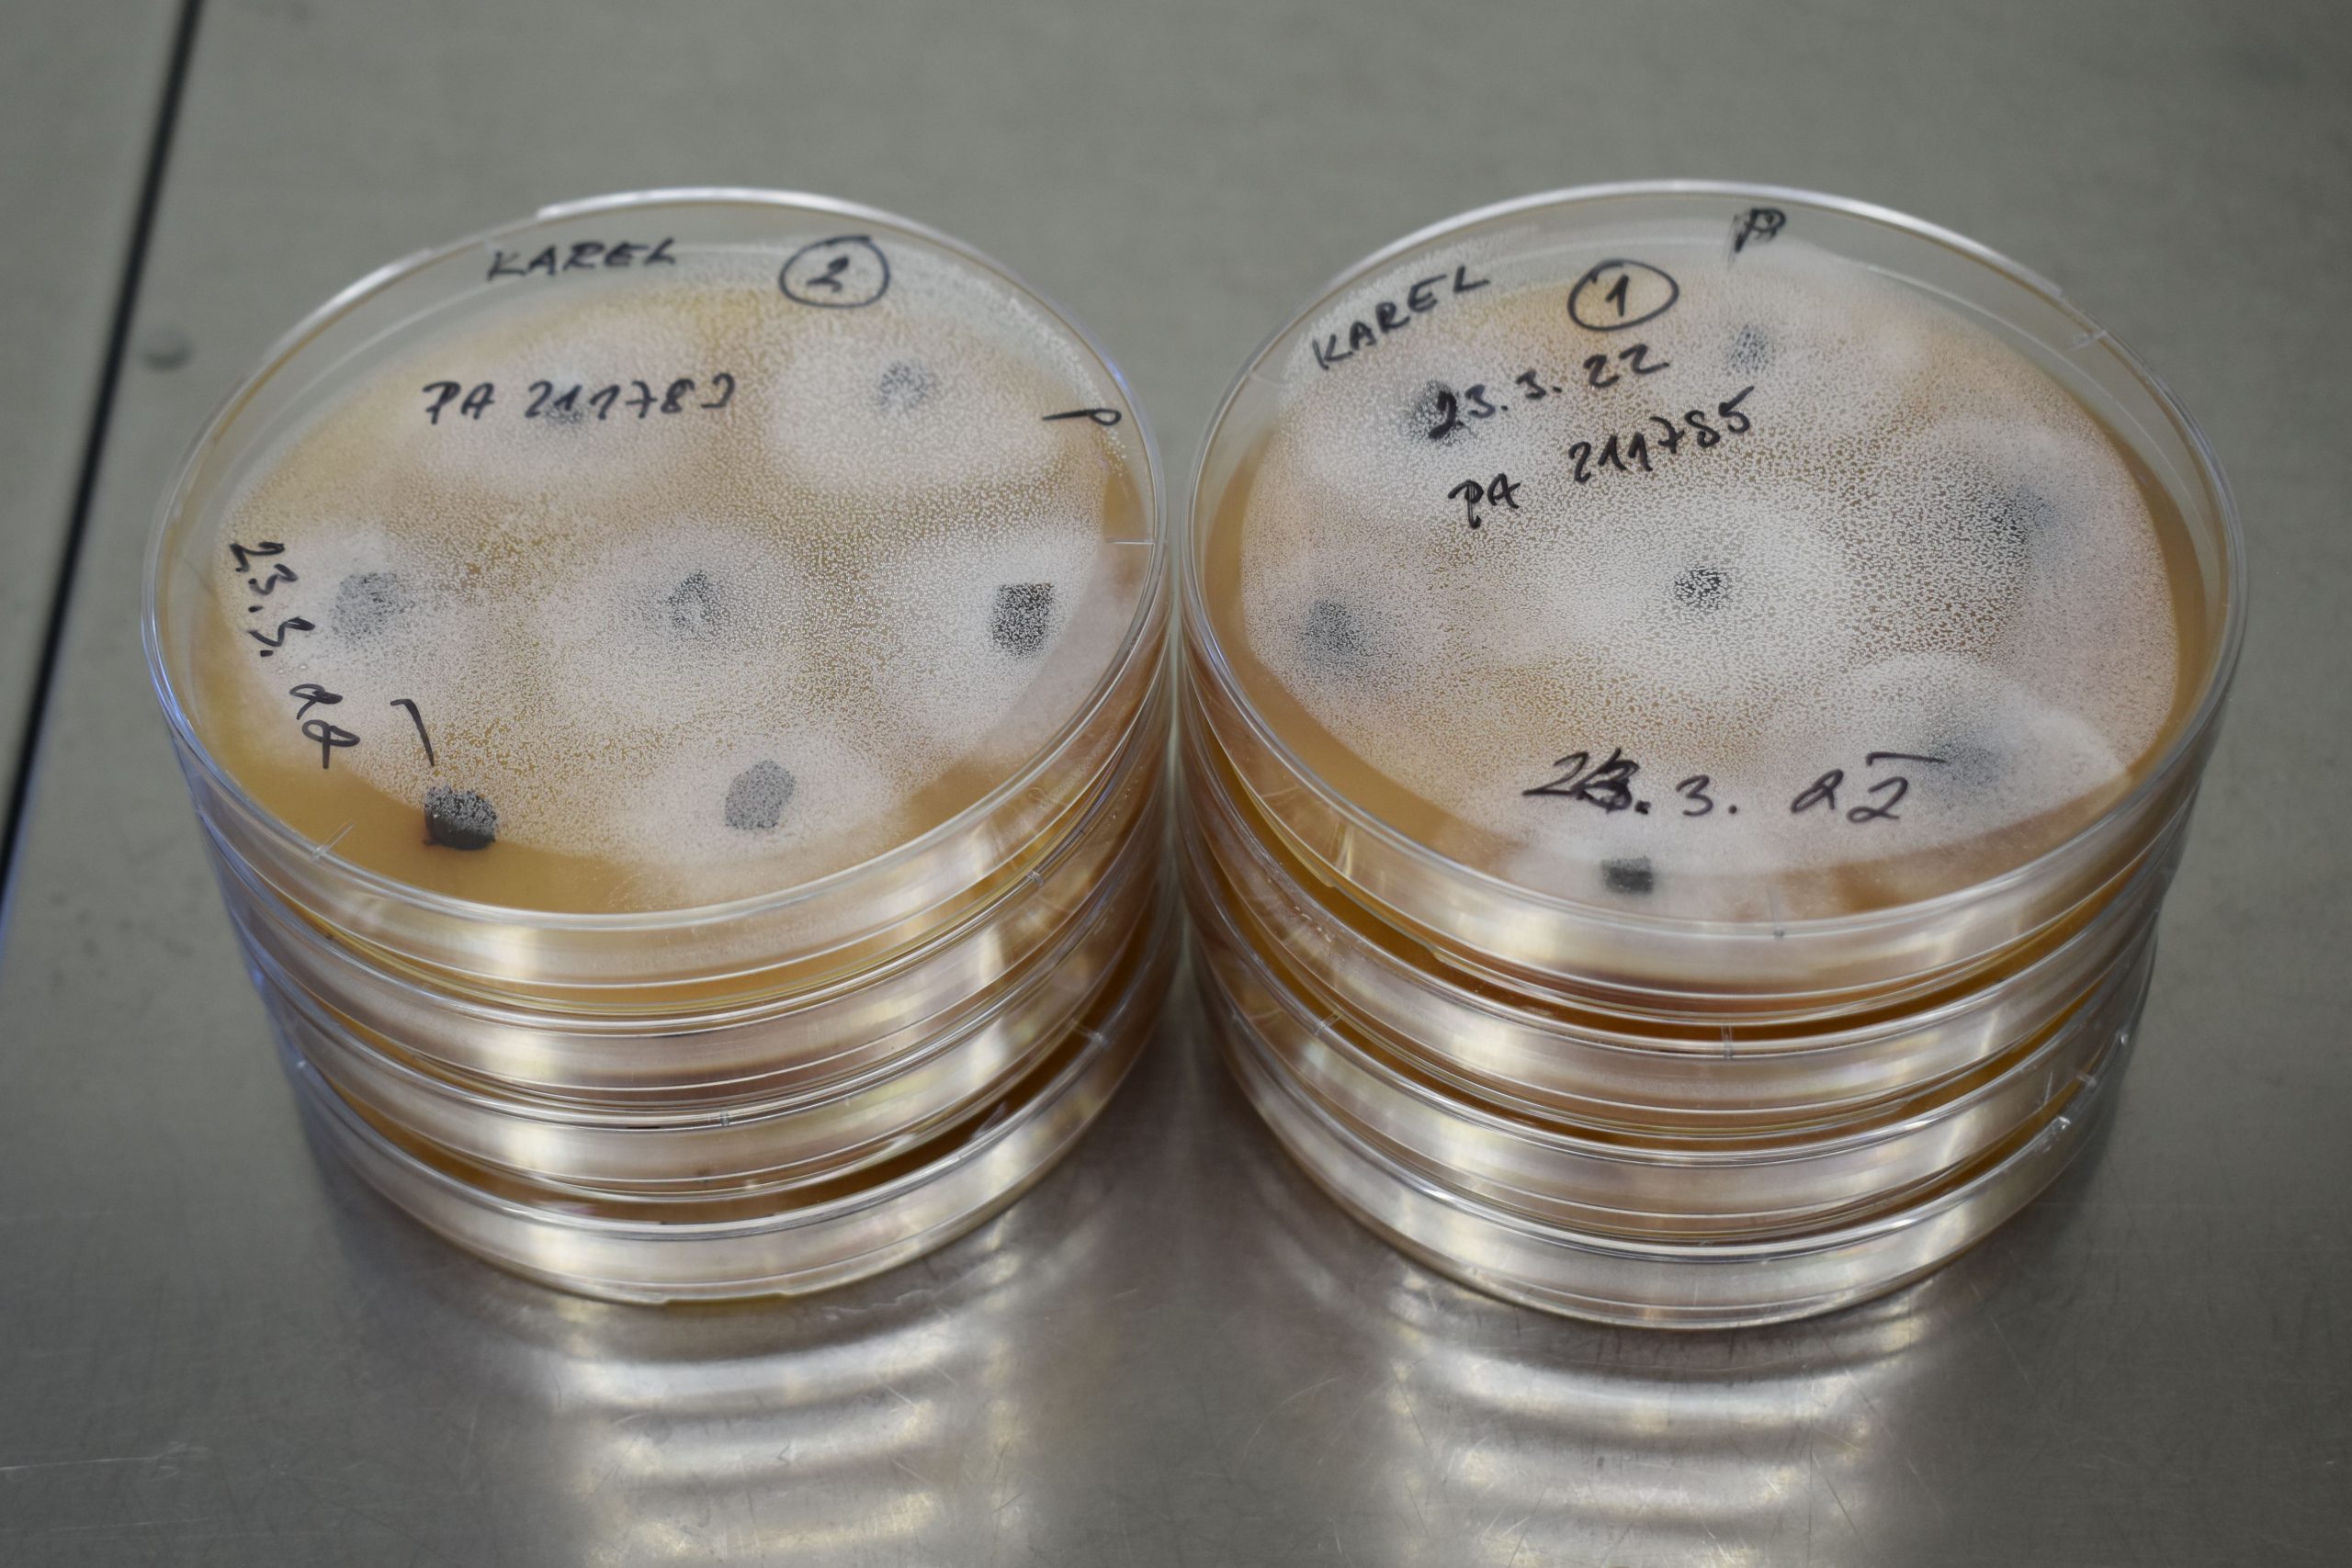
Českem se šíří plíseň olšová. Invazní patogen ohrožuje lužní a mokřadní olšiny

Výzkumníci z Odboru biologických rizik a Odboru rostlinných biotechnologií VÚK publikovali metodu...
Aktuality
Sklizeň plodin ve výzkumném agrolesnickém systému Michovky
V rámci evropského projektu DigitAF (Digital Tools to boost AgroForestry) proběhla dne 15. srpna...
Nové projekty VÚK v Národním programu Životní prostředí
Výzkumný ústav pro krajinu, v. v. i. je příjemcem dotace poskytnuté rozhodnutím ministra životního...
Dušan Romportl v ČT o celosvětové databázi střetů obratlovců s vozidly
Vedoucí Odboru prostorové ekologie VÚK Dušan Romportl představil ve vysílání České televize...
Registrace na workshop: Topol černý a jeho využití ve vodohospodářství a lesnictví
Výzkumný ústav pro krajinu, v. v. i. ve spolupráci s partnery Lesoškolky s.r.o. a Povodí Vltavy,...
V Mostě proběhla konference projektu Green Mine. Krajina po těžbě dostává novou šanci
Ve dnech 13. a 14. května 2025 se v prostorách Magistrátu města Mostu uskutečnila konference k...
Nový nástroj AgroforesTreeAdvice pomáhá farmářům vybírat vhodné dřeviny pro agrolesnictví
Výzkumníci z několika evropských institucí včetně Výzkumného ústavu pro krajinu (VÚK) představili...
VÚK se podílí na obnově lomu ČSA v rámci projektu Green Mine, proběhla výsadba rychle rostoucích dřevin
Výzkumný ústav pro krajinu (VÚK) se aktivně zapojuje do strategického projektu Green Mine, jehož...
Pamětní lavička Ing. Evy Petrové v Dendrologické zahradě
V pátek 16. 5. 2025 byla v okraji Dlouhé louky v Dendrologické zahradě v Průhonicích odhalena...
Workshop a výsadba rychle rostoucích dřevin – Věda v praxi obcí II
V rámci projektu financovaného z programu Smart Akcelerátor III – Věda v praxi obcí II...
Jarní prodej květin v areálu VÚK
Zveme Vás k letošnímu jarnímu prodeji květin! Bude probíhat v areálu skleníků VÚK v...
Obnova přírodního dědictví v Evropském Zeleném pásu – inspirativní příklady dobré praxe
Evropský Zelený pás je územím s pohnutou minulostí. Pásmo, táhnoucí se Evropou v severojižním...
Workshop Využití vrb pro haťování bystřin
Dne 25. 3. 2025 proběhl ve Výzkumném ústavu pro krajinu (VÚK) workshop projektu NAKI „Autonomní...
Britští botanici navštívili Průhonice za účelem mezinárodní spolupráce na ochraně jeřábů
Ve dnech 5. až 6. března 2025 zavítali do Výzkumného ústavu pro krajinu v Průhonicích dvě přední...
Českem se šíří plíseň olšová. Invazní patogen ohrožuje lužní a mokřadní olšiny
V důsledku globalizace obchodu s rostlinným materiálem a zavlékání nepůvodních druhů rostlin...
Metodika oceňování okrasných rostlin na trvalém stanovišti k dostání zdarma
Vychází aktualizovaná Metodika oceňování okrasných rostlin na trvalém stanovišti. Je určena k...
Zdravá a odolná krajina, kde se dobře žije. Vzniká Politika krajiny
Česká krajina čelí problémům, které ovlivňují její schopnost plnit funkce nezbytné pro lidskou...
Článek v Landscape Ecology o vlivu využívání krajiny 19. století na současnou vegetaci trávníků
Existuje vztah mezi krajinným pokryvem z poloviny 19. století a současnou vegetací trávníků? Na...
Pořádáme konferenci Politika krajiny: Krajina, která tu po nás zůstane
Zveme odbornou veřejnost, zástupkyně a zástupce krajů, měst a obcí, nevládních a profesních...
Od 1. 1. 2025 měníme název na Výzkumný ústav pro krajinu, v. v. i.
Nový název, stejné poslání. Od Nového roku bude krajinu zkoumat Výzkumný ústav pro krajinu, v. v....
Metodika identifikace topolu černého pomocí DNA markerů
Ministerstvem zemědělství byla certifikována Metodika identifikace topolu černého pomocí DNA...
Tým VÚKOZ v strategickém projektu Green Mine „vrací krajinu lidem a přírodě“
VÚKOZ se od 1. 9. 2024 zapojil do strategického projektu Green Mine, který se zabývá celkovou...
50 let ve VÚK – Rozhovor s Ivanem Sucharou
Život zasvětil vědě – ve Výzkumném ústavu pro krajinu (VÚK) se doc. RNDr. Ivan Suchara CSc. už...
Seminář: Nové poznatky a praktické zkušenosti s ochranou domácích endemických jeřábů
Dne 14. listopadu 2024 proběhl ve Výzkumném ústavu Silva Taroucy pro krajinu a okrasné...
Prodej vánočních květin ve VÚKOZ
Zveme Vás na letošní adventní prodej květin. Bude probíhat v areálu skleníků VÚKOZ v Průhonicích –...
Historické mapy a letecké snímky jako podklady pro obnovu funkcí krajiny, příklady z praxe
Kde byly dříve louky, remízky či mokřady, jsou dnes širé lány orné půdy. Krajina tak postupně...
Prezentovali jsme výsledky na konferenci GIS Esri v ČR
Zástupci VÚKOZ se ve dnech 6. a 7. listopadu zúčastnili konference GIS Esri v ČR, která se věnuje...
Seminář: Potenciál biomasy vzhledem ke kritériím udržitelnosti a aspektu využití
Ve vzdělávacím centru Floret v Průhonicích proběhl seminář s názvem Potenciál biomasy vzhledem ke...
Článek: Změna heterogenity krajiny ČR v posledních dvou stoletích
Jak se krajina České republiky proměnila za posledních dvě stě let a jaký vliv to má na...
Jak vypadala letošní vegetační sezona v českých pralesích?
Padající listí a podzimní slunce posledních dní nás vedly k zamyšlení, jaká byla uplynulá...
Výzkum protierozní funkce agrolesnických systémů
14. 10. 2024 se na našich výzkumných plochách na Michovkách uskutečnilo měření protierozní...
VÚKOZ na podzimní výstavě Flora Olomouc – Hortikomplex
Pracovníci VÚKOZ se zúčastnili podzimní výstavy Flora Olomouc – Hortikomplex, která se konala od...
Vědci vyzývají EU k naléhavé ochraně evropských pralesů
Více než 150 vědců, mezi nimi i několik zástupců Odboru ekologie lesa VÚKOZ, podepsalo dopis...
Odbor prostorové ekologie opanoval Cenu Vladimíra Krajiny
Odbor prostorové ekologie VÚKOZ opanoval Cenu Vladimíra Krajiny za vynikající publikaci v krajinné...
Spolupracujeme se Švýcarskem na rozvoji krajinné politiky
V České republice byl zahájen projekt Politika krajiny, mezi jehož cíle patří analyzovat problémy...
Zkoumáme možnosti využití biomasy při rekultivaci post-těžební krajiny a na podporu komunitní energetiky
Jak využívat potenciál energetické biomasy při rekultivaci post-těžební krajiny? Otázka, na kterou...
Odhalení pamětní lavičky prof. Ing. Jiřího Marečka, CSc. v Dendrologické zahradě
V Dendrologické zahradě v Průhonicích byla ve středu 25. září odhalena pamětní lavička věnovaná...
Odbor ekologie krajiny na konferenci EVS a IAVS
Ve dnech 16. – 20. září 2024 se na Madeiře uskutečnilo setkání vědeckých a dalších pracovníků...
Výsledkem pokusů na výzkumných plochách VÚKOZ jsou dva typy skelných hnojiv
Jsou vhodná pro zelené střechy, trvalkové záhony, mobilní zeleň i alejové stromy – řeč je o...
Mapujeme rozsah a následky povodní v krajině pomocí družicových dat
Tým dálkového průzkumu Země na VÚKOZ zmapoval pomocí aktuálních dat z družice Sentinel rozsah...